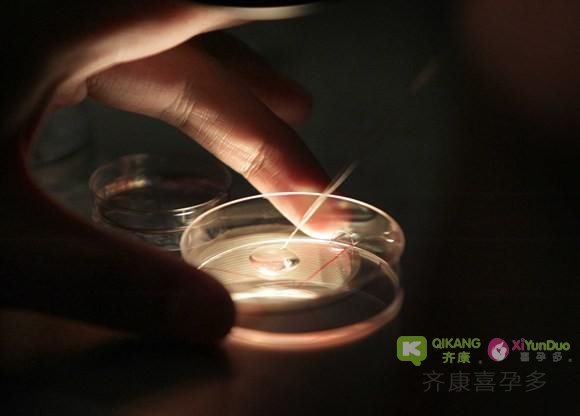

微促试管婴儿是一项试管中自身卵巢功能不稳定的人群,。不同于自然周期试管婴儿,它会使用一些口服药物刺激卵巢产生2-5个卵泡。总的来说,我们会有2-3个高质量的胚胎,微促与常规试管婴儿的区别在于注射次数不同。正常情况下一个治疗周期注射2-3次。

做微促的患者会服用叫Clomid的药物,周期第三天开始每天服一次,也可能会根据患者对Clomid的反应加2-3次生育方面的注射类药物(Gonadotropins),有些患者无需注射。用促性腺激素释放激素激动剂喷雾或注射Lupron来促进卵子成熟,而不是注射HCG。跟HCG相比,促性腺激素释放激素激动剂更符合生理学且减少卵巢囊肿风险。最重要的是,降低卵巢过度刺激综合症风险。
微促的周期很短因为只有少量卵泡。取卵一般采用局部麻醉,比静脉镇静剂或全麻更安全。然而,如果患者取卵时要求静脉镇静剂,也可提供。微促用的取卵针也要小很多,这样更安全也减少痛苦。患者治疗后就可行走自如,开车回家。

选择做微促的女性希望体验更全面和自然的诊疗过程。她们希望在生活中尽量减少化学品和药品的使用。微促相比自然周期来说,每个周期都会产生更多的高质量的卵子,增加每次取卵怀孕的可能性,同样也可能产生过剩的胚胎用来冷冻。

相对于常规试管婴儿,患者更喜欢微促是因为它降低了副作用和健康风险,因为用药量减少。常规试管婴儿中,因为用到大量的生育类药物,经常频繁的产生大量的卵泡,从而使卵巢胀大,导致腹胀腹痛,某些患者会发展成卵巢过度刺激综合症,这是非常严重的。卵巢过度刺激综合症可导致体重增加,呼吸急促且需住院治疗1-2周。微促避免了卵巢过度刺激综合症的风险并显著减少生育类药物费用。微促试管婴儿是一项新型的且非常受欢迎的诊疗形式。不同于自然周期试管婴儿,它会使用一些口服药物刺激卵巢产生2-5个卵泡。总的来说,我们会有2-3个高质量的胚胎,微促与常规试管婴儿的区别在于注射次数不同。正常情况下一个治疗周期注射2-3次。
做微促的患者会服用叫Clomid的药物,周期第三天开始每天服一次,也可能会根据患者对Clomid的反应加2-3次生育方面的注射类药物(Gonadotropins),有些患者无需注射。用促性腺激素释放激素激动剂喷雾或注射Lupron来促进卵子成熟,而不是注射HCG。跟HCG相比,促性腺激素释放激素激动剂更符合生理学且减少卵巢囊肿风险。最重要的是,降低卵巢过度刺激综合症风险。
微促的周期很短因为只有少量卵泡。取卵一般采用局部麻醉,比静脉镇静剂或全麻更安全。然而,如果患者取卵时要求静脉镇静剂,也可提供。微促用的取卵针也要小很多,这样更安全也减少痛苦。患者治疗后就可行走自如,开车回家。
选择做微促的女性希望体验更全面和自然的诊疗过程。她们希望在生活中尽量减少化学品和药品的使用。微促相比自然周期来说,每个周期都会产生更多的高质量的卵子,增加每次取卵怀孕的可能性,同样也可能产生过剩的胚胎用来冷冻。

相对于常规试管婴儿,患者更喜欢微促是因为它降低了副作用和健康风险,因为用药量减少。常规试管婴儿中,因为用到大量的生育类药物,经常频繁的产生大量的卵泡,从而使卵巢胀大,导致腹胀腹痛,某些患者会发展成卵巢过度刺激综合症,这是非常严重的。卵巢过度刺激综合症可导致体重增加,呼吸急促且需住院治疗1-2周。微促避免了卵巢过度刺激综合症的风险并显著减少生育类药物费用。